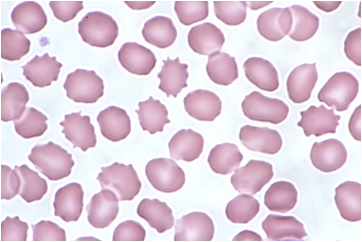

B5 CM Nephro PQ's
1/106
There's no tags or description
Looks like no tags are added yet.
Name | Mastery | Learn | Test | Matching | Spaced | Call with Kai |
|---|
No analytics yet
Send a link to your students to track their progress
107 Terms
sensorineural hearing loss, abnormal type IV collagen alpha chains, anterior lenticonus, microscopic hematuria
What symptoms are consistent with a diagnosis of Alport syndrome?
goodpasture syndrome
A 54-year-old male presents to the emergency department with a 1-day history of hemoptysis. He says he has also experienced dyspnea, fatigue, weight loss, and hematuria for the last 3 weeks. Chest radiograph reveals diffuse bilateral opacities. Kidney biopsy reveals a linear pattern of deposits on immunofluorescence staining.
The most likely diagnosis is:
Subepithelial humps of IgG and C3 on basement membrane
A 15-year-old female presents to the emergency department with brown urine for the last 3 days. She has fatigue and a headache. Additionally, she reports reduced urine output. Further history reveals that she had a recent upper respiratory infection as well as a skin rash that was treated with antibiotics around 15 days ago. Family history reveals nothing significant. A physical examination reveals a lethargic female with edema around the eyes and in the bilateral lower extremities. Laboratory studies reveal elevated BUN/creatinine, 2+ blood, 1+ protein, and RBC casts.
Biopsy is most likely to reveal:

Mesangial cell proliferation on light microscopy
A 45-year-old male presents to the office with the complaints of nausea, fatigue, edema, hypertension, and hematuria. A 24-hour urine collection shows 4.5 g of protein. Laboratory studies reveal a blood urea nitrogen/creatinine ratio of 10.0. Electron microscopy of the kidney shows an extension of a mesangial cell splitting the basement membrane.
The most likely additional finding is:
IgA Nephropathy
What disorder is associated with:
Henoch-Schonlein purpura
Post-streptococcal Glomerulonephritis
What disorder is associated with:
NAPlr and SPE B antigens
Goodpasture’s Disease
What disorder is associated with:
Anti-GBM antibodies (alpha3 chain, type IV collagen)
Lupus Nephritis
What disorder is associated with:
Wire loop deposits
Alport Syndrome
What disorder is associated with:
COL4A6, COL4A5 genes
Pauci-immune glomerular disease
What disorder is associated with:
ANCA-associated vasculitides
Membranoproliferative glomerulonephritis
A 25-year-old female presents to the office with complaints of fatigue, ankle and foot swelling, and dark and "foamy" urine. Past medical history reveals chronic hepatitis C infection. Laboratory studies reveal low serum C3 and C4 concentrations. Urinalysis reveals hematuria, and 24-hour urine collection reveals a protein level of 3.9 g/24 h (reference range: 50-80 mg/24 h). Kidney biopsy reveals basement membrane splitting and a "tram-track" appearance on both hematoxylin and eosin and periodic acid-Schiff stains.
The most likely diagnosis is
Mesangial infiltration and inflammation caused by IgA
A 21-year-old Asian female presents to the office complaining of hematuria of two days' duration. She denies dysuria, flank pain, or fever. History is unremarkable other than the fact she recovered from a "sore throat" three days ago. Physical examination reveals mild swelling around her eyes and her lower extremities. A urinalysis shows gross hematuria and a rapid strep test is negative. Osteopathic lymphatic drainage is initiated, targeting the thoracic inlet, abdominal diaphragm and bilateral lower extremities.
What is the most likely explanation for this patient's symptoms?
clear cell renal cell carcinoma
On your pathology rotation you are asked to evaluate the following slide and help make a cancer diagnosis for a patient. The pathologist you’re working with informs you it is malignant, arises in the proximal tubule, and is associated with the loss of the short arm of chromosome 3.
Based on this information you make the diagnosis of:

transitional cell carcinoma
A 72-year-old male presents to the office because he has noticed blood in his urine over the last 10 days. He has not had any pain, burning sensation, or changes in urine stream. He has smoked a pack of cigarettes daily for 45 years but quit 10 years ago. He drinks 2 to 3 beers weekly.On examination, he has no costovertebral tenderness or suprapubic tenderness. His prostate feels normal on digital rectal examination. The remainder of the examination is within normal limits. Urinalysis shows 2+ blood but otherwise is within normal limits.
The most likely diagnosis is:
smoking
A patient presents with painless hematuria and urinary frequency. You perform a urinalysis and it comes back negative for infection. You order a CT expecting a kidney stone but instead find a mass in the bladder. You diagnose the patient with bladder cancer.
Which of the following is the most common cause of this type of cancer?
CT of the abdomen
A 60-year-old male presents to the emergency department with hematuria, left-sided flank pain, and a 30-Ib weight loss, which have been occurring over the past 3 months. He is a smoker with a 50-pack-year history. He has a body mass index of 35 kg/m2. Vital signs reveal:
Physical examination is notable for an obese abdomen with left-sided tenderness and diffuse redness of skin and mucous membranes. Given this patient's clinical presentation, the most sensitive test for diagnosis of his condition is:

Autosomal dominant mutation affecting chromosome 3
A 30-year-old male presents to the office with 3 months of hematuria and intermittent, bilateral flank pain. He denies dysuria, urgency, frequency, and urinary incontinence. His medical history is remarkable for a retinal hemangioblastoma that was diagnosed and treated during childhood. He has no other medical history and does not take any medications. His brother recently underwent surgery for management of an adrenal tumor. He does not use alcohol, tobacco, or illicit drugs. Cardiopulmonary examination is unremarkable. Abdominal examination is remarkable for palpable bilateral flank masses. There is no suprapubic tenderness. Laboratory studies are remarkable for a hemoglobin of 18.5 g/dL (reference range: 14.0-18.0 g/dL).
The most likely underlying cause of this patient's symptoms is
WT1 gene on chromosome 11
A 2-year-old male is brought to the office by his mother after she found a large, palpable mass in his right flank area while bathing him. The mother also reports noticing some blood in his wet diapers. Physical examination reveals a palpable, non-tender mass in the right flank that does not cross the midline.
The gene and chromosome associated with this child's tumor are the
‘Potter’s Facies’ – low set/flat ears, micrognathia, flattened nose, limb positioning defects, abnormal eye distance
Which signs are associated with bilateral polycystic kidney disease with oligohydramnios?
megaureter, ureteral agenesis/atresia, contralateral UPJ/UVJ obstruction, vesicoureteral reflux
Which of the following are associated with multicystic dysplastic kidney?
VCUG
You are doing a rotation in pediatrics and come across a 5-year-old patient with a febrile UTI in the hospital. You read in the patient’s chart that this is not their first febrile UTI and they’re beginning to show systemic signs of kidney disease. They had a renal ultrasound earlier in the day and the findings were abnormal.
What is the next best step in diagnosing this patient?
opsoclonus myoclonus ataxia
Which of the following paraneoplastic syndromes can be associated with neuroblastomas in children?
minimal change disease
A 6-year-old boy is brought to the emergency department by his mother due to swelling around his eyes and legs. The mother reports that the patient recently recovered from an upper respiratory tract infection. Physical exam is significant for periorbital and lower extremity edema. Laboratory testing is significant for hypoalbuminemia and normal complement levels. Urinalysis demonstrates 4+ protein.
What is the most likely diagnosis?
minimal change disease
A two-year-old female is brought to the office by her father, who has noticed increased swelling in her arms, legs, and stomach for the past week. Physical examination reveals 3+ pitting edema and ascites. Urinalysis reveals 4+ proteinuria. Laboratory studies reveal;
Albumin = 2 (reference range 3.5-5.2)
BUN = 4 (reference range 5-25)
Creatinine = 0.9 (reference range 0.17-1.36)
What is the most likely diagnosis?
reduced plasma proteins
A 54-year-old male presents to the office with weight gain and fatigue. His medical history includes diabetes mellitus. Physical examination reveals bilateral 2+ pitting edema of the lower extremities. Laboratory studies reveal hyperlipidemia and anemia. A 24-hour urine collection reveals 4,200 mg of protein (reference range: 50–80 mg). Osteopathic intervention is planned to balance the autonomic nervous system and maximize the lymphatic system's ability to mobilize fluid trapped in the intercellular space.
The most likely factor contributing to this patient's edema is:
Areas of mesangial collapse with sclerosis with some glomeruli
A 54-year-old African American female with a history of human immunodeficiency virus (HIV) infection diagnosed 25 years ago presents with periorbital and +2 pitting edema in the lower extremities for the past 3 months. She is on antiretroviral therapy but her compliance has been poor during the past 2 years. Examination reveals blood pressure of 190/95 mmHg, decreased breath sounds at the bases, and a small abdominal fluid wave. Urinalysis reveals 4+ proteinuria (> 3000 mg/24 h [reference range 50-80 mg/24 h at rest]) and hyaline and waxy casts, without hematuria. The proteinuria is nonselective, with large amounts of both albumin and globulin. A renal ultrasound shows slightly enlarged kidneys bilaterally. Labs are remarkable for blood urea nitrogen of 42 mg/dL (reference range 6-20 mg/dL), creatinine of 3.2 mg/dL (reference range 0.6-1.1 mg/dL), and total cholesterol of 298 mg/dL (reference range < 200 mg/dL).
Which of the following is the most likely finding on renal biopsy?
it follows an autosomal dominant inheritance pattern
A 36-year-old male presents to the emergency department with right-sided flank pain and bloody urine. His pain began early this morning, and he describes it as coming in waves. He noted bloody urine after the onset of the pain. He denies burning with urination or penile discharge. He has had no new sexual partners and has no history of sexually transmitted diseases. His past medical history reveals hypertension that is well-controlled on lisinopril. An abdominal and pelvic ultrasound is performed and reveals bilaterally enlarged kidneys with numerous variably sized anechoic lesions within the parenchyma.
Which of the following is true regarding the most likely etiology of this patient's disease process?
subarachnoid hemorrhage and berry aneurysms
A 65-year-old male dies of chronic renal failure. His past medical history includes hypertension, recurrent flank pain with hematuria, and mitral valve prolapse. His family history is positive for renal failure. An autopsy is performed, which reveals the lesions shown in the exhibit.
Which of the following is most strongly associated with this patient's underlying disorder?

Mutations in the PKD gene impair, polycystin protein function
A 35-year-old male presents to the office with bilateral abdominal pain and hematuria, progressing during the past 2 months. He states that the pain is located over his flank and is relatively unchanged based on position or time of the day. He has not taken any over-the-counter medications, but heating pads provided no relief. Vital signs reveal a blood pressure of 150/90 mmHg. Physical and osteopathic examination reveals abdominal fullness, with maximal tenderness to palpation at the level of T10 and a discrete somatic dysfunction at that level. Costovertebral angle tenderness is mildly present bilaterally. An abdominal CT scan is obtained as shown in the exhibit. The patient states that his father also had "cysts on his kidneys" but passed away suddenly at 42 years of age.
Which of the following is true regarding this person's disease state?

single layer of cuboidal cells, with a thin rim of fibrous tissue
A 34-year-old female presents to the emergency department with left-sided flank pain and gross hematuria. She describes a gradual onset of flank pain after a strenuous cycling workout yesterday. Vital signs reveal a blood pressure of 162/94 mmHg. Physical examination reveals a midsystolic click followed by a late systolic murmur at the apex. Laboratory studies reveal a serum creatinine of 1.2 mg/dL (reference range: 0.6–1.1 mg/dL), and urinalysis reveals 10–25 red blood cells (RBC) per high-power field (hpf) (reference range: 0–2 RBC/hpf). Ultrasound of the abdomen reveals bilaterally enlarged kidneys with copious anechoic lesions as well as numerous well-demarcated, anechoic lesions within the pancreas and liver.
What histological pattern is most likely to be seen under light microscopy if a liver lesion were biopsied?
post-renal
A 60-year-old man presents with lower abdominal pain. His symptoms have progressively worsened over the course of the day. Medical history is significant for benign prostatic hyperplasia on tamsulosin. His blood pressure is 144/106 mmHg (normally, his blood pressure is 120/80 mmHg). On physical examination he has bladder distension. Laboratory testing is significant for a creatinine of 2.4 mg/dL (last serum creatinine was 0.7 mg/dL.)Renal Ultrasound revealed enlarged prostate and enlarged bladder with bilateral hydronephrosis.
What is the most likely cause of the patient’s acute kidney injury (AKI)?
tubular epithelial cell necrosis
A 71-year-old female presents to the emergency department with a 1-day history of worsening dyspnea and pleuritic chest pain. Vital signs reveal:
-BP 132/80
-HR 120
-RR 26
-O2 86%
CT angiography of the chest reveals the presence of a right-sided pulmonary embolism. She is admitted to the hospital and started on treatment with unfractionated heparin. Her condition begins to improve; however, on hospital day 2, her urine output begins to decline. Laboratory studies reveal a blood urea nitrogen of 30 mg/dL (reference range: 6–20 mg/dL) and a creatinine of 2.2 mg/dL (reference range: 0.7–1.3 mg/dL). Urinalysis reveals granular casts, a urine sodium of 52 mEq/L (reference range: < 40 mEq/L), and a fractional excretion of sodium of > 2%. Which of the following histopathologic findings would most likely be observed in this patient's kidneys?
muddy brown casts
A 43-year-old man presents to the emergency department with lethargy, fever, chills, hypotension, and respiratory failure. Past medical history reveals tobacco abuse and reactive airway disease. He is transferred to the intensive care unit and intubated shortly after presentation. He is given appropriate intravenous hydration as he is diagnosed with septic shock, pneumonia, and acute respiratory distress syndrome. He is started on clindamycin, vancomycin, propofol, and a norepinephrine drip. The norepinephrine drip is successfully discontinued after 48 hours of hospitalization, but the patient remains intubated and sedated. On hospital day 3, the patient's urine output declines to 12 mL in the last 8 hours. On evaluation, the patient is sedated and appears edematous. Vital signs reveal appropriate limits. The patient is afebrile and normotensive. There is no rash but generalized anasarca is noted. Examination of the chest reveals coarse breath sounds and inspiratory crackles throughout both lungs. Laboratory studies reveal:

Given the most likely diagnosis, urinalysis is most likely to reveal
atheroembolic disease
A 77-year-old male presents to the office for follow-up after undergoing coronary angiography via femoral approach for stable angina 4 days ago. He feels well today and has no concerns. Past medical history reveals hypertension, hyperlipidemia, and type 2 diabetes mellitus. Vital signs and physical examination are normal. Laboratory studies reveal a blood urea nitrogen of 30 mg/dL (reference range: 6–20 mg/dL) and a serum creatinine of 2.7 mg/dL (reference range: 0.7–1.3 mg/dL). Prior to catheterization, his serum creatinine was 1.0 mg/dL. A renal biopsy is obtained, as shown in the exhibit.
The most likely cause of this patient's acute kidney injury is

granular casts
A 45-year-old male presents to the emergency department after being found unconscious and hypotensive after a skiing accident. He is given several units of packed red blood cells and saline boluses before being transferred to a regional intensive care unit. After 24 hours, his urine output has dropped to less than 400 mL/day (reference range: 800-2000 mL/day) and is dark in color.
The most likely finding to be seen in a urinalysis for this patient is
stage 3a
A 55 yo male with a past medical history of Type 2 Diabetes and Hypertension presents to the family medicine clinic to review labs. The patient had routine labs done because at his last diabetes check, he had microalbumin in his urinesample. CMP reveals a GFR of 48 with electrolytes within normal limits.
What stage of Chronic Kidney Disease does this patient have?
decreases phosphate reabsorption in the kidneys
A 45-year-old male presents to the office with nausea and bilateral leg pain. Past medical history reveals chronic kidney disease. Laboratory studies reveal an elevated parathyroid hormone level. Leg radiographs reveal cystic bone lesions bilaterally.
The hormone elevated in this patient:
inulin
A 63-year-old woman presents to the office for regular monitoring of her chronic kidney disease. She has been on hemodialysis for the past 5 years. As part of her management, creatinine, blood urea nitrogen, electrolytes, and glomerular filtration rate are monitored.
The most accurate evaluation of glomerular filtration rate is provided by clearance of:
broad waxy casts
A 65-year-old female with diabetes presents with anorexia, nausea, and confusion. She has had poorly controlled diabetes for 35 years. Physical examination reveals hypertension and 2+ pitting edema of the lower extremities to the knees. Lab studies reveal:


Ultrasound of the kidneys shows small, bilateral echogenic kidneys without evidence of hydronephrosis. Which of the following will most likely be found on urinalysis?
normocytic normochromic anemia
A 65-year-old male presents to a primary care clinic for his first checkup in 25 years. He complains of nausea, vomiting, and anorexia that have been present for the last 6 months. In addition, he reports difficulty sleeping, which he attributes to severe, diffuse itchiness. His medical history is significant for type 2 diabetes mellitus. He does not take any medications currently but admits to being on insulin in the past after he failed treatment with metformin. On examination, the patient has a thin body habitus and flaky skin with excoriations on his bilateral arms and legs. A blood smear is shown in the exhibit.
The most likely additional finding is
hyperphosphatemia
A 63-year-old female with a history of type 2 diabetes mellitus and uncontrolled hypertension presents to the office complaining of weakness and confusion. Her serum creatinine level has been slowly increasing over the last decade due to poor compliance with her medications, and her current estimated GFR is 21 mL/min (reference range: >60 mL/min). On exam, there is paravertebral hypertonicity from T11-L1 and a tender nodule just lateral and superior to the umbilicus on the right.
Which of the following laboratory findings is most likely present in this patient?
Folate; 1mg/day
Which water soluble vitamin is lost at a higher rate during dialysis than in normal patients and therefore needs supplementation?
How much of this vitamin should you supplement in your patient on dialysis?
86.4g
72kg x 1.2g = 86.4g
You are managing a patient with end stage renal disease on hemodialysis. This patient weighs 72kg and you’re tasked with determining his dietary needs.
Which of the following best represents the amount of protein this patient should consume?
Increase dietary intake of Ca2+, restrict dietary PO4, supplement Vit D3
What dietary change will help prevent renal osteodystrophy in your patient with end stage renal disease?
Limit meat to 3-4oz/day, avoid high potassium fruits and vegetables, avoid using salt and salt substitutes
Which of the following represents an accurate recommendation for dialysis patients in emergency situations where they cannot receive dialysis treatment for 5 days or less?
edema, hematuria, azotemia, oliguria, hypertension
Based on lab findings, thorough history and physical exam, you diagnose your patient with a nephritic syndrome.
Which of the following would you expect to find?
Order a renal biopsy
A 27-year-old woman presents with a 2-week history of lower extremity swelling, foamy urine, and fatigue. She reports joint pain and a facial rash that worsens with sun exposure.
Vital Signs: BP 152/94 mmHg, HR 82 bpm, Temp 99.2°F.
Physical Exam: Malar rash, bilateral lower extremity edema.
Labs: BUN 36 mg/dL, Creatinine 2.0 mg/dL. Urinalysis shows hematuria, proteinuria, and red blood cell casts. Serum testing is positive for ANA and anti–double-stranded DNA antibodies, with low complement (C4).
What is the next best step?
wire looping of capillaries
A 27-year-old woman presents with a 2-week history of lower extremity swelling, foamy urine, and fatigue. She reports joint pain and a facial rash that worsens with sun exposure.
Vital Signs: BP 152/94 mmHg, HR 82 bpm, Temp 99.2°F.
Physical Exam: Malar rash, bilateral lower extremity edema.
Labs: BUN 36 mg/dL, Creatinine 2.0 mg/dL. Urinalysis shows hematuria, proteinuria, and red blood cell casts. Serum testing is positive for ANA and anti–double-stranded DNA antibodies, with low complement (C4).
What would you expect to find under light microscope?
C3
An 8 year old boy is brought to the office due to acute facial puffiness. His mother reports that he has been fatigued and has had dark urine. The patient was treated for a skin infection 3 weeks ago but has no chronic medical conditions. Temperature is 97 F, BP is 140/94. PE shows periorbital edema and mild pitting edema along the ankles. Renal biopsy was performed and the sample is shown below.
The fluorescent areas on the slide most likely indicate the presence of which of the following substances?

IgA nephropathy/Berger’s disease
A 20-year-old college student presents with gross hematuria that began 2 days ago. He recently recovered from a sore throat. He has no past medical history and takes no medications. Physical exam is normal, with stable blood pressure and no edema. Laboratory studies reveal normal complement levels. A renal biopsy is performed and immunofluorescence shows mesangial deposition of IgA with associated C3.
Which of the following is the most likely diagnosis?
IgG immune complex
A 7 year old boy is brought to the clinic by his parents after he developed red urine earlier in the day. The patient has a history of atopic dermatitis. He had a skin infection one month ago that was treated with a short course of antibiotics. BP 140/90. On PE, there is periorbital edema, pitting edema on both feet. Lab results show elevated BUN/creatinine.
What might you see in the glomerular basement membrane?
type III hypersensitivity
A 7 year old boy is brought to the clinic by his parents after he developed red urine earlier in the day. The patient has a history of atopic dermatitis. He had a skin infection one month ago that was treated with a short course of antibiotics. BP 140/90. On PE, there is periorbital edema, pitting edema on both feet. Lab results show elevated BUN/creatinine.
What type of hypersensitivity reaction is occuring?
Membranoproliferative glomerulonephritis
A 25 year old female presents to the office with complaints of fatigue, ankle and foot swelling, and dark and foamy urine. PMHx reveals chronic hepatitis C infection. Lab studies reveal low serum C3 and C4 concentrations. Urinalysis reveals hematuria, and 24-hour urine collection reveals a protein level of 3.9g/24h (reference range: 50-80). Kidney biopsy reveals basement membrane splitting and a “tram-track” appearance on both hematoxylin & eosin and periodic acid-schiff stains.
The most likely diagnosis is:
Diffuse proliferative glomerulonephritis
45 year old African American female presents to office with blood in her urine. She has no significant past medical history. Family history reveals sarcoidosis in her mother. Vital signs reveal BP 155/90. Lab studies reveal proteinuria (2.4 g protein), positive anti-double stranded DNA antibodies, and low complement C3 and C4 levels. An US-guided biopsy was performed. A tissue section representative of the remaining tissue is shown in the exhibit. The most likely diagnosis is:

Cytoplasmic antineutrophil cytoplasmic antibodies (C-ANCA)
A 45 year old woman presents to the office with fever, malaise, and a recent 10 lb weight loss. She reports recurrent upper respiratory tract infections, including sinusitis and several episodes of hemoptysis in the past year. She has developed intermittent hematuria in the past few weeks. Vital signs revealed a temperature of 102.2 F. PE reveals decreased breath sounds with crackles bilaterally. Urinalysis is positive for microscopic hematuria, proteinuria and RBC casts. The patient subsequently undergoes bronchoscopy which reveals diffuse erythema of the tracheobronchial mucosa.
Lab studies would most likely reveal:
Alport Syndrome
A 12-year-old boy is evaluated for recurrent episodes of gross hematuria, most often following upper respiratory tract infections. His mother reports that he has also been struggling in school because of progressive hearing difficulties. Family history reveals that two maternal uncles developed kidney failure in early adulthood. On exam, his blood pressure is 145/92 mmHg. Urinalysis shows hematuria with red blood cell casts and mild proteinuria. Laboratory studies demonstrate normal complement levels. Renal biopsy reveals irregular thickening, thinning, and splitting of the glomerular basement membrane with a “basket-weave” appearance on electron microscopy.
Which of the following is the most likely diagnosis?

type IV collagen
A 12-year-old boy is evaluated for recurrent episodes of gross hematuria, most often following upper respiratory tract infections. His mother reports that he has also been struggling in school because of progressive hearing difficulties. Family history reveals that two maternal uncles developed kidney failure in early adulthood. On exam, his blood pressure is 145/92 mmHg. Urinalysis shows hematuria with red blood cell casts and mild proteinuria. Laboratory studies demonstrate normal complement levels. Renal biopsy reveals irregular thickening, thinning, and splitting of the glomerular basement membrane with a “basket-weave” appearance on electron microscopy.
The mutated gene codes for:
anti-GBM antibody deposits visible using renal biopsy immunofluorescence
A 27 year old male presents to the office with complaints of fatigue, hemoptysis and dark urine for the past month. He denies nasal discharge or oral ulcers and has not had arthralgia or rashes. He has not experienced any weight loss or malaise. Labs show worsening of his baseline kidney function, and urinalysis reveals mild proteinuria and RBC casts.
Which of the following would be most consistent with your diagnosis?
Pulmonary hemorrhage
If the previous patient with goodpasture’s disease (anti-GBM disease) waited weeks longer to get treatment, which of the following findings is associated with the worst prognosis?
Areas of mesangial collapse with sclerosis within some glomeruli
A 54 year old African American female with a history of HIV infection diagnosed 25 years ago presents with periorbital and 2+ pitting edema in the lower extremities for the past 3 months. She is on antiretroviral therapy but her compliance has been poor during the past 2 years. Examination reveals BP of 190/95, decreased breath sounds at the bases and a small abdominal fluid wave. Urinalysis reveals 4+ proteinuria and hyaline and waxy casts without hematuria. The proteinuria is nonselective, with large amounts of both albumin and globulin. A renal ultrasound shows slightly enlarged kidneys bilaterally. Labs are remarkable for BUN 42 mg/dL (reference range 6-20), creatinine 3.2 mg/dL (reference range 0.6-1.1), and total cholesterol of 298 mg/dL (reference range <200).
Which of the following is the most likely on renal biopsy?
Low C3 with normal C4
A 6-year-old boy develops edema and dark-colored urine 2 weeks after a skin infection. Urinalysis shows proteinuria and hematuria with red blood cell casts. Renal biopsy reveals enlarged, hypercellular glomeruli with neutrophil infiltration. Electron microscopy shows subepithelial “hump-shaped” deposits.
Which complement abnormality is most likely present?
Transurethral resection of bladder tumor (TURBT)
A 58-year-old male smoker presents with painless gross hematuria. He denies dysuria or flank pain. Cystoscopy reveals a papillary lesion in the bladder. Biopsy confirms a non–muscle invasive papillary urothelial carcinoma.
What is the most appropriate next step in management?
PCT
A 64-year-old man with a history of chronic renal failure and long-term dialysis presents with painless hematuria. CT imaging reveals a solid renal mass. Biopsy shows papillary fronds lined by cuboidal cells with eosinophilic cytoplasm.
This neoplasm most commonly arises from which of the following renal structures?
Stage T3; radical cystectomy with pelvic lymphadenectomy
A 70-year-old Egyptian man presents with gross hematuria and irritative urinary symptoms. He reports a history of chronic Schistosoma haematobium infection. Cystoscopy and biopsy reveal invasive squamous cell carcinoma of the bladder invading into perivesical tissue, without nodal or metastatic disease.
What is the correct staging and treatment?
Tuberous Sclerosis
Von Hippel Lindau
Smoking (#1)
Hypertension
Birt-Hogg-Dube
Polycystic Kidney Disease
Horseshoe Kidney
Obesity
Which of the following is associated with increased risk of Renal Cell Carcinoma?
Renal medullary carcinoma with aggressive clinical course
A 35-year-old man presents with worsening left flank pain and unintentional weight loss. He emigrated from the United States to Nigeria for work 2 years ago. His medical history is notable only for a remote diagnosis of sickle cell trait. Labs show mild normocytic anemia and elevated LDH. CT abdomen demonstrates an infiltrative renal mass centered in the medulla, extending into perinephric fat. Histopathology reveals poorly differentiated carcinoma with stromal desmoplasia and tumor cells showing hobnail morphology.
Which of the following is the most likely diagnosis?
Neoadjuvant cisplatin-based chemotherapy followed by radical cystectomy
A 61-year-old man presents with painless hematuria. He has a 40–pack-year smoking history and worked as a truck driver for 30 years. Cystoscopy reveals a large, sessile bladder mass. TURBT is performed, and pathology shows muscle-invasive high-grade urothelial carcinoma (T2). CT chest/abdomen/pelvis shows no evidence of nodal disease or distant metastases. His renal function is normal.
Which of the following is the most appropriate next step in management?
It is best treated with partial or radical cystectomy with en bloc resection of the urachus and umbilicus
A 55-year-old man presents with gross painless hematuria. Urine cytology reveals mucin-producing cells, and serum studies show an elevated CEA. Cystoscopy demonstrates a cystic mass involving the dome of the bladder extending into the urachus. Biopsy reveals a high-grade adenocarcinoma.
Which of the following is the most accurate statement regarding this patient’s tumor?
Clear cell renal cell carcinoma associated with the loss of VHL gene on chromosome 3p
A 42-year-old man presents for evaluation of multiple bilateral renal masses discovered incidentally on abdominal imaging. Family history is significant for a father who died of a brain tumor and a sister who has retinal angiomas. Genetic testing confirms a mutation.
Which of the following renal tumors is this patient most likely at risk of developing?
Secretion of vasoactive intestinal peptide (VIP)
A 14-month-old boy presents with abdominal distension and watery diarrhea. Exam shows a firm abdominal mass crossing the midline. Laboratory studies reveal hypokalemia. CT abdomen demonstrates a large adrenal mass with calcifications. Urine studies are positive for elevated homovanillic acid (HVA) and vanillylmandelic acid (VMA).
Which paraneoplastic syndrome is most likely responsible for this child’s diarrhea?
microcephaly, frontal bossing
Which of the following is NOT typically associated with Potter’s syndrome?
Stage I; surgical excision only
A 4-year-old girl is brought to the pediatrician after her mother noticed a firm abdominal mass while bathing her. Physical exam reveals a non-tender flank mass that does not cross the midline. Abdominal ultrasound shows a large renal mass confined to the left kidney with an intact capsule. CT confirms no peritoneal involvement or distant metastasis. Which of the following best describes the stage and appropriate treatment for this patient?
Beckwith-Wiedemann syndrome (WT2 abnormality, 11p15)
A 3-year-old girl is evaluated for developmental delay and seizures. On exam, she has hemihypertrophy of the right arm and leg, macroglossia, and a firm left-sided abdominal mass. Ultrasound confirms a large renal tumor. Genetic testing shows chromosomal abnormalities. Which of the following syndromes is most consistent with her presentation?

Germline mutation of the WT1 gene on chromosome 11p13 associated with WAGR syndrome
A 4-year-old boy is brought to the pediatrician because of an enlarging abdominal mass noticed by his parents during bathing. The mass is smooth, firm, and does not cross the midline. His blood pressure is elevated at 132/88 mmHg. On exam, he also has aniridia and undescended testes.
Laboratory studies are normal except for mild anemia. Abdominal CT shows a large, well-circumscribed renal mass confined to the right kidney without nodal disease. Biopsy reveals a triphasic pattern with blastemal, stromal, and epithelial elements. Which of the following best describes the underlying molecular pathogenesis of this patient’s tumor?

First child: Wilms tumor → nephrectomy with chemotherapy; Second child: Neuroblastoma → risk-stratified multimodal therapy including surgery, chemotherapy, and stem cell transplant if high-risk
A 3-year-old girl is brought in for evaluation of an abdominal mass. On exam, the mass is smooth, firm, and does not cross the midline. Blood pressure is elevated, and labs reveal mild anemia. Abdominal CT shows a well-circumscribed renal mass confined to the kidney.
A different 2-year-old boy presents with a large abdominal mass that is irregular, firm, and crosses the midline. His parents report episodes of watery diarrhea and flushing. CT shows a large adrenal mass with calcifications. Urine studies demonstrate elevated homovanillic acid (HVA) and vanillylmandelic acid (VMA). Which of the following statements correctly matches each child’s diagnosis and management strategy?
corticosteroids
A 6-year-old boy presents with periorbital edema two weeks after an upper respiratory infection. Labs show: albumin 1.9 g/dL, normal creatinine, normal complement, and urinalysis with 4+ protein. Kidney biopsy is normal by light microscopy, but electron microscopy shows diffuse effacement of foot processes. Which of the following is the best initial treatment?

Primary membranous nephropathy
A 48-year-old man presents with nephrotic-range proteinuria. A renal biopsy demonstrates subepithelial immune complex deposits and thickening of the glomerular basement membrane. Antibodies against the phospholipase A2 receptor are identified. Which of the following is the most likely underlying diagnosis?
Circulating immune complexes in the setting of systemic lupus erythematosus
A 42-year-old woman presents with new-onset leg swelling and frothy urine. She has no history of diabetes or hypertension. Exam shows periorbital edema and blood pressure of 132/80 mmHg. Labs: serum albumin 1.8 g/dL, cholesterol 310 mg/dL, creatinine 0.9 mg/dL. Urinalysis: 4+ protein, no hematuria. ANA is positive at 1:640. Renal biopsy reveals subepithelial immune deposits and diffuse thickening of the glomerular basement membrane. Which of the following best explains the pathogenesis of this patient’s renal disease?
Renal vein thrombosis due to urinary loss of antithrombin III
A 35-year-old woman with known nephrotic syndrome develops sudden left flank pain and gross hematuria. Labs show elevated LDH and low haptoglobin. Renal ultrasound demonstrates no hydronephrosis. Which of the following is the most likely explanation?
AL amyloidosis from light-chain deposition due to plasma cell dyscrasia
A 68-year-old man presents with progressive lower extremity edema, fatigue, and back pain. On exam, he has pallor and reduced sensation in his feet. Renal biopsy shows amorphous deposits that stain positively with Congo Red but are negative for immune complex deposition.
Hemoglobin: 9.8 g/dL
Creatinine: 2.0 mg/dL
Albumin: 2.1 g/dL
Serum protein electrophoresis: monoclonal spike
Urinalysis: 4+ protein, no hematuria
24-hour urine: predominantly non-albumin protein
Which of the following best explains this patient’s renal disease?
no screening needed
A 24-year-old man presents to clinic because his father and paternal aunt both required dialysis in their 50s due to kidney failure. He has no current symptoms and denies hematuria, flank pain, or urinary tract infections. Physical exam is normal. He is otherwise healthy and is concerned about whether he should be tested for kidney disease.
What is the most appropriate next step in this patient’s evaluation?
Congenital hepatic fibrosis with portal hypertension
A 6-year-old boy is brought in for evaluation of growth delay and abdominal swelling. His parents note that he has had difficulty feeding since infancy and frequent respiratory infections. On exam, he has bilateral flank masses and hepatomegaly. His blood pressure is 128/82 mmHg (elevated for age). Lab work shows BUN 40 mg/dL and creatinine 2.3 mg/dL. Urinalysis is bland, without significant proteinuria or hematuria. Ultrasound reveals bilaterally enlarged, diffusely echogenic kidneys with poor corticomedullary differentiation. MRI shows dilated collecting ducts.
Which of the following is most strongly associated with this patient’s condition?
berry aneurysm, mitral valve prolapse, hepatic cysts, abdominal wall inguinal hernias
A 40-year-old with a known history of a genetically inherited kidney disease presents for follow-up. They have well-controlled hypertension and report no current urinary symptoms. PE is unremarkable and their most recent CT is obtained.
Which of the following is an extra-renal manifestation most commonly associated with this condition?

Perform unilateral nephrectomy of the larger kidney prior to transplant
A 52-year-old man with autosomal dominant polycystic kidney disease presents for evaluation prior to kidney transplantation. He has been experiencing increasing abdominal discomfort, early satiety, and recurrent episodes of urinary tract infections. Imaging studies reveal markedly enlarged bilateral polycystic kidneys, with the right kidney significantly larger than the left. His kidney function continues to decline despite optimal medical management. In addition, concerns regarding limited retroperitoneal space for placement of a donor kidney have been raised. Which of the following is the most appropriate clinical intervention to facilitate successful transplantation?
Chronic dialysis leads to nephron loss and compensatory tubular hyperplasia, triggering activation of proto-oncogenes and a 4-7% risk of renal cell carcinoma over 10 years
A 55-year-old man with end-stage renal disease secondary to hypertension presents for his annual follow-up. He has been on hemodialysis for the past 11 years. He reports feeling well overall with no new complaints. A recent renal ultrasound demonstrates multiple small bilateral renal cysts, and the kidneys are of normal size. There is no family history of kidney disease. Which of the following best describes the pathogenesis and the associated risk for renal cell carcinoma in this patient?
It results from abnormal differentiation of metanephric parenchyma
A 2-week-old male is evaluated for a palpable abdominal mass noted on routine newborn exam. The infant is otherwise healthy, with normal feeding and urination. On exam, there is a firm, irregular, non-tender mass in the left flank. Blood pressure is normal. Ultrasound of the kidneys shows multiple non-communicating cysts of varying size replacing the renal parenchyma on the left side, while the right kidney appears hypertrophied.
Which of the following is most accurate regarding this patient’s condition?
No treatment, reassurance only
A 62-year-old man undergoes abdominal ultrasound as part of an evaluation for nonspecific abdominal discomfort. The study shows a 2.5 cm, well-circumscribed, anechoic lesion in the left kidney. CT confirms that the lesion is filled with clear fluid and has a smooth wall without septations or enhancement. The patient’s renal function is normal, and he has no hematuria, flank pain, or family history of kidney disease.
Which of the following is the most appropriate management for this patient?
Initiate angiotensin-converting enzyme inhibitor therapy, increase fluid intake
A 36-year-old man with a strong family history of autosomal dominant polycystic kidney disease (ADPKD) presents for routine follow-up. He was diagnosed several years ago after an incidental finding of multiple bilateral renal cysts on ultrasound. Over the past year, his blood pressure has risen gradually and is now 148/92 mm Hg. He also reports intermittent mild flank discomfort and occasional headaches. His physical exam reveals bilateral flank fullness without tenderness, and laboratory tests, including renal function, are within normal limits. In an effort to manage his blood pressure and potentially slow the progression of renal dysfunction, a pharmacologic intervention is considered.
Which of the following is the most appropriate pharmacotherapeutic choice for this patient?
PKD2 mutation on chromosome 4
A 52-year-old man presents for evaluation of worsening flank pain and elevated blood pressure. He reports a family history of kidney disease in his mother, who developed renal failure in her late 60s. On exam, his blood pressure is 158/94 mmHg. Laboratory results show BUN 38 mg/dL and creatinine 2.1 mg/dL. Renal ultrasound reveals bilaterally enlarged kidneys with numerous cysts in both the cortex and medulla. Compared to patients with other genetic variants of this condition, he is noted to have later onset of renal failure and a milder clinical course.
Which of the following best describes the underlying genetic abnormality in this patient?
stage 1
A 62-year-old man is admitted to the hospital with septic shock secondary to pneumonia. Over the past 10 hours, his urine output has been measured at 0.4 mL/kg/hr. His baseline serum creatinine is 1.0 mg/dL, and today it is 1.6 mg/dL.
Which of the following is the most appropriate KDIGO stage of acute kidney injury (AKI) for this patient?
ACE inhibitor–induced decreased GFR
A 54-year-old woman with a history of hypertension and osteoarthritis presents with generalized weakness and decreased urine output over the past 24 hours. She has been taking her home medications, which include lisinopril and ibuprofen for chronic knee pain. She denies vomiting, diarrhea, or recent illness.
On exam:
BP: 110/68 mmHg
HR: 88 bpm
Lungs: clear
Cardiac exam: normal
Extremities: no edema
Labs:
Creatinine: 2.0 mg/dL (baseline 0.9 mg/dL)
BUN: 45 mg/dL
FeNa: 0.5%
Urinalysis: no casts
Which of the following is the most likely cause of this patient’s acute kidney injury?
pre-renal
A 72-year-old man presents with dizziness and decreased urine output after a week of severe diarrhea from gastroenteritis. On exam, his BP is 88/56 mmHg, HR 112 bpm, mucous membranes are dry, and JVP is low.
Labs: Creatinine 2.2 mg/dL (baseline 0.9), BUN 50 mg/dL, FeNa 0.3%, bland urinalysis.
What kind of AKI is happening?
post-renal
A 68-year-old man with a history of benign prostatic hyperplasia presents with suprapubic pain, inability to urinate, and lower abdominal distension.
Vitals: BP 148/96 mmHg. On exam, bladder is palpable and tender.
Labs: Creatinine 2.6 mg/dL (baseline 0.8). Renal ultrasound shows bilateral hydronephrosis.
What kind of AKI is happening?
intra-renal
A 64-year-old woman with diabetes presents after being treated with gentamicin for a urinary tract infection. She now reports reduced urine output and generalized weakness.
Labs: Creatinine 3.1 mg/dL (baseline 1.0), BUN 36 mg/dL, FeNa 3.4%. Urinalysis shows muddy brown casts.
What kind of AKI is happening?
Normocytic normochromic anemia
A 65-year-old male presents to a primary care clinic for his first checkup in 25 years. He complains of nausea, vomiting, and anorexia that have been present for the last 6 months. He also reports difficulty sleeping due to severe, diffuse pruritus. His past medical history is significant for type 2 diabetes mellitus. He does not take any medications currently but states that he previously required insulin after failing treatment with metformin. On examination, the patient has a thin body habitus and flaky skin with excoriations on his bilateral arms and legs.
What is the most likely diagnosis of this patient?
Begin diuretic therapy with IV furosemide
A 70-year-old man with a history of long-standing hypertension and ischemic cardiomyopathy presents with worsening shortness of breath, orthopnea, and bilateral leg swelling. On exam, he has elevated jugular venous pressure, bilateral crackles in the lungs, and 2+ pitting edema in the lower extremities. His urine output has decreased over the past 24 hours. Laboratory studies show:
Creatinine: 2.1 mg/dL (baseline 1.0 mg/dL)
BUN: 46 mg/dL
Urine sodium: 8 mEq/L
Which of the following is the most appropriate initial management for this patient’s acute kidney injury?
Start an angiotensin-converting enzyme (ACE) inhibitor
A 56-year-old man with type 2 diabetes presents for his annual follow-up. He has no significant symptoms but routine labs reveal a urine albumin-to-creatinine ratio (ACR) of 120 mg/g and an eGFR of 95 mL/min/1.73 m². Blood pressure is 142/88 mm Hg.
Which of the following interventions is the most appropriate next step to slow the progression of his kidney disease?
Intravenous iron dextran
A 62-year-old woman with stage 4 chronic kidney disease (GFR <30 mL/min/1.73 m²) presents with fatigue and pallor. Laboratory evaluation shows:
Hemoglobin: 8.1 g/dL
Mean corpuscular volume (MCV): 88 fL
Ferritin: 150 ng/mL (normal)
Transferrin saturation: 30% (normal)
Which of the following is the most appropriate management for this patient’s anemia?
Implement dietary phosphate restriction combined with sevelamer and vitamin D supplementation
A 58-year-old man with a 10-year history of chronic kidney disease presents with generalized bone pain and muscle weakness. He has been receiving regular hemodialysis and recently noted a decrease in his appetite. His physical exam is unremarkable aside from diffuse bone discomfort.

Which of the following interventions best addresses these derangements by targeting phosphate accumulation and vitamin D deficiency as well as mitigating secondary hyperparathyroidism?
Stage 3 CKD: Moderate reduction in eGFR with moderately increased albuminuria
A 52-year-old man with a 10-year history of type 2 diabetes mellitus and hypertension presents for a routine evaluation. He is asymptomatic and notes no changes in his overall health. His blood pressure is 138/85 mm Hg. eGFR is 55 and ACR is 150.
Which of the following CKD stage classifications best describes this patient’s condition?